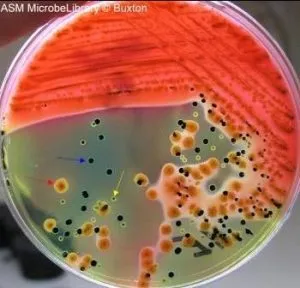
Hektoen enteric agar colonies - Stool culture on Hektoen enteric agar: mixed flora including Escherichia coli (red arrow), Salmonella (blue arrow), and Proteus vulgaris (yellow arrow).
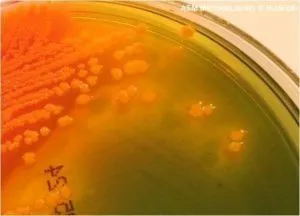
yellow-orange colonies of Proteus vulgaris in Hektoen Enteric Agar - Yellow-orange colonies ofProteus vulgarisin Hektoen Enteric Agar

Hektoen Enteric (HE) Agar was introduced in 1968 by Sylvia King and William I. Metzger. They formulated HE Agar medium while working at the Hektoen Institute in Chicago, to increase the recovery Salmonella and Shigella from clinical specimens.  It is a selective as well as a differential culture medium.
They enriched the media with extra amounts of carbohydrates and peptones to offset the inhibitory effects of the bile salts. The two dyes added to the media, bromthymol blue and acid fuchsin, have lower toxicity than other dyes. Thus pathogen recovery improves. HE agar is currently applicable as both direct and indirect plating medium for fecal specimens to enhance the recovery of species of Salmonella and Shigella from heavy numbers of mixed normal fecal flora.
Purpose
Hektoen enteric agar is currently applicable as a direct and indirect plating medium to recover gastrointestinal pathogens, such as Salmonella and Shigella, from food, water, and fecal samples suspected of containing these organisms.
- Selective medium: It inhibits most nonpathogenic (normal flora) enteric organisms and assists in selective recovery ofSalmonella and Shigellafrom feces.
- Differential medium: It allows microbiologists to note visual differences in colony morphology and quickly eliminate nonpathogenic gram-negative rods from pathogenic gram-negative rods with minimal additional testing.
HE agar can be used for the primary plating of fecal specimens. It may also be useful to subculture the overnight growth from enrichment broths (such as gram-negative broth or selenite broth) inoculated with fecal specimens suspected of containing low numbers of Salmonella. Direct inoculation of colonies from agar plates may produce sufficient growth of organisms that would otherwise be inhibited in a more dilute inoculum from diarrheal feces or broth culture.
Principle
Hektoen enteric agar is a selective as well as differential media for the isolation and differentiation of enteric pathogens from clinical specimens.
The presence of the bile salts and dyes inhibits most gram-positive organisms allowing only gram-negative rods to grow on HE agar. The high concentration of bile salts partially or fully inhibits most of the nonpathogenic coliform flora of the intestinal tract. Since the enteric pathogens, Salmonellaand Shigellacan tolerate these inhibitory substances they generally grow faster and larger than the coliforms.
Composition of Hektoen Enteric Agar
- Protease, peptone, and yeast extracts: Animal peptones and yeast extract provide the nutritional base.
- Â Sodium chloride
- Â **Bile salts:**The high bile salt concentration inhibits the growth of all gram-positive bacteria and retards the growth of many strains of coliforms.
- Sodium thiosulfate (sulfur source) and ferric ammonium citrate: HE agar can detect the production of H2S by specific enteric gram-negative rods, like Salmonella. This is due to the addition of thiosulfate and ferric ammonium citrate to the formula. Salmonella produces bacterial enzymes that releases a sulfide molecule from the thiosulfate present in the media. This sulfide molecule then couples with a hydrogen ion to form H2S gas. The H2S gas reacts with the ferric ammonium citrate. The reaction forms a precipitate, resulting in black colonies or a black center. Other nonpathogenic enteric organisms, such as Proteus spp. and Citrobacter freundii, also produce H2S, but the bile salts in the HE agar usually inhibit these organisms. If these organisms can overcome the inhibitory effects of the bile salts and grow, they usually can be differentiated from the pathogens because Proteus andCitrobacter freundii can utilize at least one of the carbohydrates present in the HE agar. An orange-yellow colony with a black center is most likely not an intestinal pathogen, although rare strains of Salmonellaare capable of lactose fermentation and would appear this way.
-
Carbohydrates: The fermentation of carbohydrates (lactose, sucrose, and salicin), is one of the differentiating characteristics used to identify coliforms. Salmonella and Shigella are unable to utilize these three specific carbohydrates. Whereas most nonpathogenic coliforms can use at least one of them. There may be production of acids by carbohydrates fermentation. So, acid fuchsin reacting with thymol blue produces the yellow color when the pH lowers.
-
Dyes used: Bromthymol blue and Acid fuchsin
Nonpathogenic coliforms (if they are able to grow in the presence of the bile salts) will produce orange-yellow colonies. This is due to the production of acid from at least one of the carbohydrates. This acid causes the bromthymol blue indicator to change from its neutral green color to orange-yellow color. The bile salts may precipitate out of the media and appear as a hazy zone around the colonies. If lactose- and sucrose-negative organism utilizes salicin, salmon-pink to orange-yellow colonies will be present. The inability of Salmonella and Shigella to produce acid results in colonies that are translucent, light green, or greenish-blue. This quality allows them to be quickly differentiated from nonpathogenic organisms.
Since HE agar is primarily a screening agar, you need to perform additional testing to confirm or rule out Salmonella orShigella. Several options are available for confirmatory testing like commercial identification kits to tubed biochemical (e.g., TSI, urea agar, lysine decarboxylase). The serological typing of somatic and capsular antigens are also available.
Colony Characteristics
- Rapid lactose fermenters (such as E.coli) are moderately inhibited and produce bright-orange to salmon pink colonies.
- Salmonellacolonies are blue-green typically with black centers from hydrogen sulphide gas.
- Shigellaappear greener than Salmonella, with the color fading to the periphery of the colony.
- Proteus strains are somewhat inhibited. Colonies that develop are small transparent and more glistening or watery in appearance than species of Salmonella or Shigella.
References
- Goo, V. Y., Ching, G. Q., & Gooch, J. M. (1973). Comparison of brilliant green agar and Hektoen enteric agar media in the isolation of salmonellae from food products. Applied microbiology, 26(3), 288–292. https://doi.org/10.1128/am.26.3.288-292.1973
- King, S., & Metzger, W. I. (1968). A new plating medium for the isolation of enteric pathogens. I. hektoen enteric agar. Applied microbiology, 16(4), 577–578. https://doi.org/10.1128/am.16.4.577-578.1968